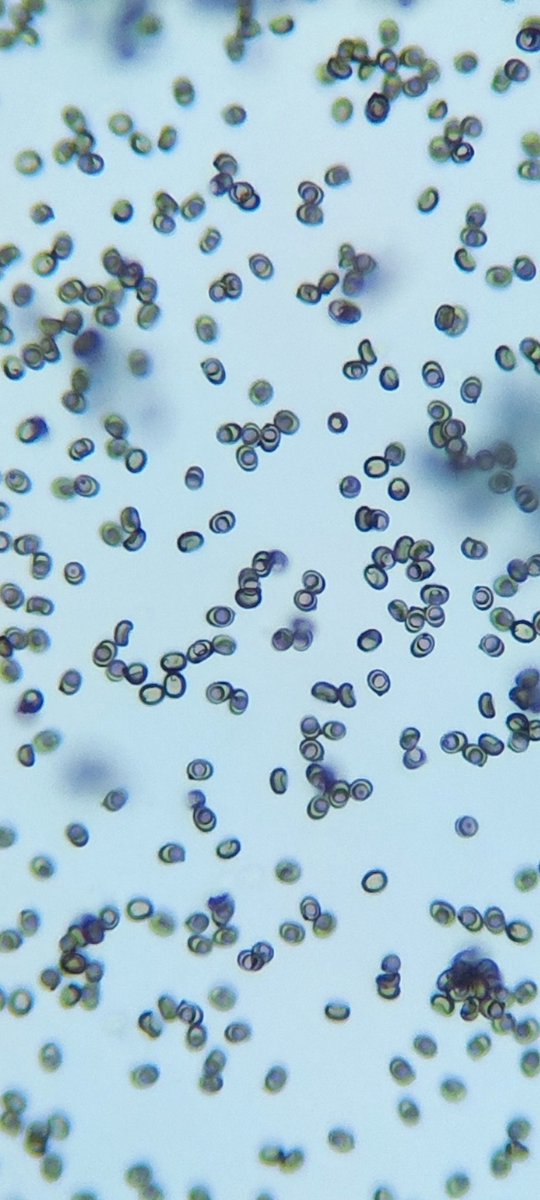
Alicia Giner tweet media

Alicia Giner retweetledi
Alicia Giner
1.3K posts


Alicia Giner
@AliceGiner
Profesora de Biología y Geología. Paleontóloga. Apasionada por la divulgación científica y la fotografía. Estudiante de doctorado (UV)
Valencia, Spain Katılım Kasım 2017
357 Takip Edilen562 Takipçiler


@ClaraGrima ¡¡Enhorabuena, @ClaraGrima !! 😍 Sin duda, una manera fantástica de celebrar el 11 de febrero. Felicidades, te lo mereces😘😘😘
Español

En esta fecha, tan maravillosamente especial, el #11defebrero de 2026, se ha inaugurado en mi pueblo, Coria del Río, el Centro de Formación Clara Grima Ruiz.
Aún estoy flotando en una nube.
Ha sido uno de los mejores momentos de mi vida a nivel personal y profesional ❤️




Español
Alicia Giner retweetledi

Habían transcurrido 23 años desde que concluyese su expedición a bordo del Beagle.
Charles Darwin publicó #TalDíaComoHoy de 1859 la primera edición de "El origen de las especies por medio de la selección natural".

Español
Alicia Giner retweetledi

Comenzamos una nueva charla del ciclo Nuestro hogar en la Vía Láctea. El Sistema Solar.
Hoy damos un paseo por Marte de la mano de Francisco González @iaa_csic
Podéis seguirla en directo y participar en el chat
youtube.com/live/Kzuedtytf…

YouTube

Español
Alicia Giner retweetledi

@AliceGiner CIENCIA, y el "azar relativo"
El libro homenaje a Albert Einstein y Niels Bohr el centenario de sus premios Nobel
cienciayelazarrelativo.blogspot.com
CIENCIA, y otras "Easy Pieces"
El libro homenaje a las Lectures de Feynman
cienciayotraseasypieces.blogspot.com
Y
cienciaylacuantica.blogspot.com



Español
Alicia Giner retweetledi

Bergara, la cuna del wolframio, se convierte en el epicentro de la ciencia durante el primer fin de semana de octubre.
En el marco de los XII Premios Ciencia Jot Down @JotDownSpain, el @BergaraMuseoa celebra su décimo aniversario.
laboratorium.eus/es/los-xii-pre…

Español

¡Super feliz de conocer a @ClaraGrima en persona! ¡Espectacular ponencia! #JotDown Ciencia 2025

Bergara, España 🇪🇸 Español

¡Allá vamos!
Laboratorium Museoa@BergaraMuseoa
(Cas) 📆 ¡Los días 3 y 4 de octubre Bergara se convertirá en epicentro científico mundial! Habrá ponencias, diversas actividades... ¡y se celebrará Bedelkar Jaia! 🎊 ✍️ Es necesaria la inscripción en las actividades, consulta la web: 🔗 laboratorium.eus/es/premios-jot…
Español
Alicia Giner retweetledi

«El código W» de @AliceGiner ha sido el relato ganador del concurso de divulgación Ciencia Jot Down con la temática «Elementos críticos: del wolframio a las tierras raras» en la modalidad de narrativa. @DIPCehu @BergaraMuseoa @unisevilla @labsubcanfranc
revistamercurio.es/2025/09/10/el-…
Español
Alicia Giner retweetledi

Felicidades a los ganadores del Concurso Ciencia Jot Down 2025 @DivuLCC @AliceGiner y Amanda Salas
@meneame_net @DIPCehu @BergaraMuseoa @labsubcanfranc @unisevilla @revistamercurio
jotdown.es/2025/09/fallo-…
Español